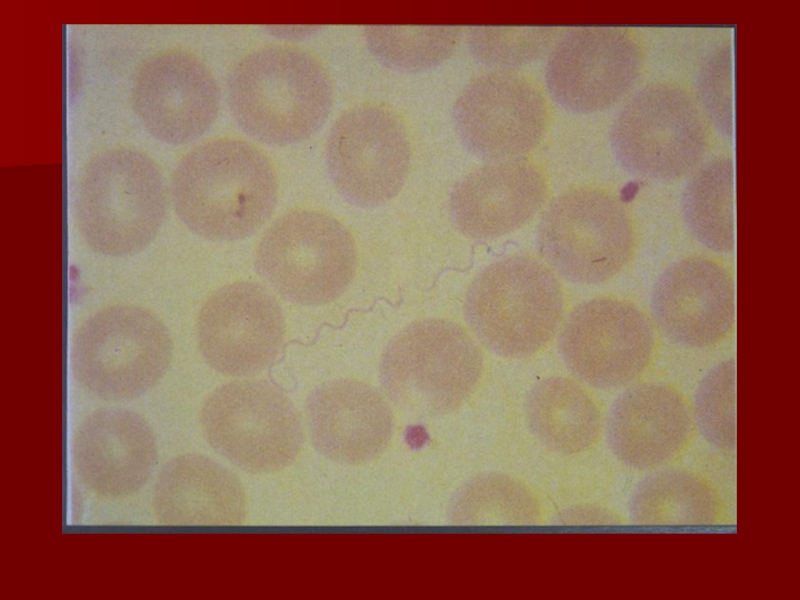

Разделы презентаций
- Разное
- Английский язык
- Астрономия
- Алгебра
- Биология
- География
- Геометрия
- Детские презентации
- Информатика
- История
- Литература
- Математика
- Медицина
- Менеджмент
- Музыка
- МХК
- Немецкий язык
- ОБЖ
- Обществознание
- Окружающий мир
- Педагогика
- Русский язык
- Технология
- Физика
- Философия
- Химия
- Шаблоны, картинки для презентаций
- Экология
- Экономика
- Юриспруденция
Лекция № 23
Содержание
- 1. Лекция № 23
- 2. Основные отличия от других прокариотдлинные (3 – 500 мкм)извитые
- 3. Особенности ультраструктуры спирохетцитоплазматический цилиндр переплетён с одной
- 4. Особенности ультраструктуры спирохетна противоположенных концах клетки –
- 5. Слайд 5
- 6. Слайд 6
- 7. Слайд 7
- 8. Типы движения спирохетвращательноесгибательноештопоро(винто-)образное
- 9. Таксономия патогенных спирохетGracilicutesSpirochaetalesSpirochaetaceaeTreponemaBorreliaLeptospiraceaeLeptospira
- 10. Тинкториальные свойства спирохетплохо воспринимают анилиновые красители (кроме
- 11. ТРЕПОНЕМЫ
- 12. Патогенные виды трепонемT.pallidumподвид pallidum (сифилис)подвид pertenue (тропическая гранулёма = фрамбезия)подвид endemicum (беджель = эндемичный сифилис)
- 13. Патогенные виды трепонемT. carateum (пинта = карате)T. vincentii (+ F. nucleatum = язвенно-некротическая ангина)
- 14. T. pallidum, вариант pallidum: морфологияот 8 до
- 15. Слайд 15
- 16. Слайд 16
- 17. T. pallidum, вариант pallidum: культивирование«культуральные трепонемы» -
- 18. T. pallidum, вариант pallidum: биохимические свойстваизучены мало
- 19. T. pallidum, вариант pallidum: антигенная структураплохо изученасложнаизвестны:трепонематозный
- 20. T. pallidum, вариант pallidum: факторы вирулентностиустойчивость к фагоцитозувысокая инвазивная активностьэндотоксинлипопротеины (участвуют в развитии иммунопатологических процессов)
- 21. С И Ф И Л И С
- 22. Сифилис: взаимодействие возбудителя с организмом человекаразмножение трепонем
- 23. Сифилис: общая характеристика заболеванияциклическоестадии (периоды) не всегда сменяются последовательнообразование L-форм и цист
- 24. Сифилис: периодыинкубационныйпервичный сифилисвторичный сифилистретичный сифилиснейросифилис (четвертичный сифилис)
- 25. Слайд 25
- 26. Сифилис: протяжённость инкубационного периодаот 10 до 90 сутокв среднем – 24 дняИлл.
- 27. Сифилис: характеристика первичного периодав месте внедрения возбудителя
- 28. Твёрдый шанкр
- 29. Сифилис: характеристика вторичного периоданаступает через 6-7 недель после появления твёрдого шанкрарецидивирующая сыпьИлл.
- 30. Слайд 30
- 31. Слайд 31
- 32. Сифилис: исходы вторичного периода25 % - выздоровление25
- 33. Сифилис: характеристика третичного периоданаступает обычно через 3-4
- 34. Слайд 34
- 35. Характеристика нейросифилисаразвивается у некоторых больных при неадекватном лечениинаступает в среднем через 8-15 леттяжёлое поражение ЦНСИлл.
- 36. Слайд 36
- 37. Врождённый сифилис: условия возникновенияинфицирование плода во вторую
- 38. Врождённый сифилис: последствия внутриутробного инфицирования плодаИлл.
- 39. Сифилис: особенности иммунитетавосприимчивость человека к сифилисуклеточный ИОинфекционная аллергия (ГЗТ)гуморальный ИОпостинфекционный иммунитетвысокафиксация (гранулёмы)не элиминируютне эффективенне формируется
- 40. Сифилис: механизм формирования рецидивирующей сыпивысота ИОобразование цистснижение напряжённости ИОвозврат в вегетативную формустадия ремиссиирецидив
- 41. Сифилис: источник и механизм передачиисточник инфекции –
- 42. Сифилис: устойчивость возбудителя к факторам внешней средымалоустойчив
- 43. Сифилис: профилактикаНеспецифическаяпостоянный половой партнёрвыявление и лечение больныхобследованиедоноровбеременных
- 44. Лечение сифилисаАнтибиотики пенициллинового рядаИлл.
- 45. Микробиологическая диагностика сифилиса: методы
- 46. Микроскопическое выявление T. pallidumмикроскопия нативного препарта в тёмном поледлительная окраска по Романовскому-Гимзеобработка серебрением (по Морозову)
- 47. Слайд 47
- 48. Слайд 48
- 49. Слайд 49
- 50. Оценка микроскопической картины при выявлении T. pallidumдифференциация от нитей фибринадифференциация сапрофитических трепонем от T. pallidum
- 51. Дифференциация сапрофитических трепонем от T. pallidumна
- 52. Серологический метод диагностики сифилисаНеспецифические тесты (с кардиолипиновым
- 53. БЫТОВЫЕ ТРЕПОНЕМАТОЗЫ
- 54. Бытовые трепонематозы: распространениефрамбезия – тропические страныпинта –
- 55. Бытовые трепонематозы: пути зараженияфрамбезия – контактный (очень
- 56. Бытовые трепонематозы: клинические проявленияфрамбезия – как при
- 57. Бытовые трепонематозы: диагностикафрамбезия – пинта –
- 58. Бытовые трепонематозы: лечениефрамбезия – пинта – беджель – аналогично сифилисуИлл.
- 59. БОРРЕЛИИ
- 60. Основные группы патогенных для человека боррелийвозбудитель эпидемического
- 61. Свойства боррелийпохожи на червейстрогие анаэробысреды с животными белками, куриные эмбрионы
- 62. Антигенная структура боррелийсложнаявнутригеномная рекомбинация → чрезвычайная вариабельность
- 63. ЭПИДЕМИЧЕСКИЙ ВОЗВРАТНЫЙ ТИФ
- 64. Эпидемический возвратный тиф: этиологияBorrelia recurrentis (размножается в гемолимфе платяных вшей)
- 65. Эпидемический возвратный тиф: взаимодействие возбудителя с организмом
- 66. Слайд 66
- 67. Эпидемический возвратный тиф: микробиологическая диагностикакровь (приступ)
- 68. Слайд 68
- 69. Слайд 69
- 70. КЛЕЩЕВЫЕ СПИРОХЕТОЗЫ
- 71. Клещевые спирохетозы: эндемичные очагирасположены на всех континентах, кроме Австралиидля каждого природного очага – свой вариант возбудителя
- 72. Клещевые спирохетозы: возбудителиB. duttoniB. uzbekistanicaB. persicaB. caucasicaи др.друг от друга отличаются антигенной структурой
- 73. БОЛЕЗНЬ ЛАЙМА
- 74. Болезнь Лайма: этиологияB. burgdorferiB. gariniiB. afzeliiдруг от друга отличаются антигенной структурой
- 75. Слайд 75
- 76. Слайд 76
- 77. Болезнь ЛаймаИсточники инфекции – мелкие грызуны, олени,
- 78. Слайд 78
- 79. Болезнь Лайма: взаимодействие возбудителя с организмом человекаукус клеща (слюна)папулакровьпоражения внутренних органов(аутоиммунный компонент)
- 80. Слайд 80
- 81. Болезнь Лайма: общая характеристика болезниЛокальное поражение кожи (кольцевая мигрирующая эритема)Поражение (хронический процесс):суставовсердечно-сосудистой системынервной системыN
- 82. Слайд 82
- 83. Болезнь Лайма: микробиологическая диагностикаВыделение культуры из ткани
- 84. ЛЕПТОСПИРЫ
- 85. Лептоспиры: общая классификацияLeptospira водные
- 86. Лептоспиры: морфологические свойстватолщина 0,1 мкмзавитки первого порядка
- 87. Слайд 87
- 88. Лептоспиры: основной способ микроскопического выявленияТёмно-польная микроскопия «раздавленной капли»
- 89. Слайд 89
- 90. Слайд 90
- 91. Лептоспиры: культуральные свойствамикроаэрофилы30о Сжидкие и полужидкие среды с сывороткой кролика (напр., Уленгута)~ неделяне мутят (микроскопия)
- 92. Серогруппы и серовары патогенных лептоспирболее 200 сероваровв СНГ – 27объединены в 38 серогруппв СНГ - 13
- 93. Чувствительность лептоспир к факторам внешней средысолнечный светвысокая температуравысушиваниедезинфектантыДолго сохраняются в заболоченной почве (до 200 суток)
- 94. Факторы патогенности лептоспирэндотоксинобщая интоксикациягеморрагиивысокая подвижностьинвазивностьустойчивость к фагоцитозуферменты вирулентностифибринолизинплазмокоагулазалипазацитотоксины и гемолизинN
- 95. Распространение лептоспирПовсеместное
- 96. ЛЕПТОСПИРОЗ
- 97. Лептоспироз: особенности инфицирования человекаживотныес мочойинфицирование объектов внешней средыводы (чаще)почвыпищевых продуктовконтакт человекаслизистыеповреждённая кожа
- 98. Взаимодействия лептоспир с организмом человекапокровылимфаnodulus кровьсосудыпеченьпочкиЦНСгеморрагиижелтухав мочеменингизм
- 99. Слайд 99
- 100. Патогенез поражения при лептоспирозе сосудовмеханическое воздействие на эндотелийнарушение проницаемости стенкимножественные геморрагииИлл.
- 101. Патогенез поражения при лептоспирозе печенимеханическое повреждение гепатоцитов активно подвижными лептоспирамитоксическое действие метаболитов и продуктов распада лептоспирИлл.
- 102. Патогенез поражения при лептоспирозе почекизбирательное депонирование лептоспирна поверхности эпителиальных клетокв межклеточном пространстветяжёлое повреждение почечных канальцевнарушение мочеобразованияИлл.
- 103. Патогенез поражения при лептоспирозе ЦНСнепосредственное действие самих бактерийдействие их токсиновдействие продуктов распада бактериальных клетокменингиальные явленияИлл.
- 104. Препараты для иммунопрофилактики лептоспирозаубитая поливалентная вакцинаиммуноглобулин
- 105. Лабораторная диагностика лептоспироза: общая схемапатологический материал
- 106. Лабораторная диагностика лептоспироза: патологический материалкровь – 1 неделямоча – со 2 неделиliquor – при менингиальных симптомах
- 107. Лабораторная диагностика лептоспироза: микроскопический метод«раздавленная капля»микроскопия в тёмном поле– малочувствителен– недостаточно специфиченN
- 108. Лабораторная диагностика лептоспироза: культуральный методсреда Уленгутамикроскопия каждые 2 дняреакция микроагглютинации и лизиса
- 109. Слайд 109
- 110. Лабораторная диагностика лептоспироза: биологический методвнутрибрюшинноморская свинкапотеря весажелтухаэкссудат из брюшной полостиРМАиЛкультура
- 111. Лабораторная диагностика лептоспироза: серологический методсо второй недели
- 112. Спасибо за внимание
- 113. Скачать презентанцию
Слайды и текст этой презентации
Слайд 3Особенности ультраструктуры спирохет
цитоплазматический цилиндр переплетён с одной или несколькими осевыми
фибриллами (состоят из флагеллина)
(блефаропласту, как у простейших)Слайд 4Особенности ультраструктуры спирохет
на противоположенных концах клетки – по блефаропласту, соответственно
две фибриллы (или два пучка фибрилл) направлены с противоположенных концов
клетки и пересекаются в её серединедвижение – за счёт сокращения самого тела клетки
клеточная стенка грамотрицательного типа
Слайд 9Таксономия патогенных спирохет
Gracilicutes
Spirochaetales
Spirochaetaceae
Treponema
Borrelia
Leptospiraceae
Leptospira
Слайд 10Тинкториальные свойства спирохет
плохо воспринимают анилиновые красители (кроме Borrelia)
основной (и дифференцирующий)
метод окраски – по Романовскому-Гимзе
по Морозову (Treponema)
тёмно-польная микроскопия
Слайд 12Патогенные виды трепонем
T.pallidum
подвид pallidum (сифилис)
подвид pertenue (тропическая гранулёма = фрамбезия)
подвид
endemicum (беджель = эндемичный сифилис)
Слайд 13Патогенные виды трепонем
T. carateum (пинта = карате)
T. vincentii (+ F.
nucleatum = язвенно-некротическая ангина)
Слайд 14T. pallidum, вариант pallidum: морфология
от 8 до 14 равномерных завитков
по
3 периплазматических жгутика
может образовывать L-формы (свёрнутые в шар трепонемы, покрытые
непроницаемой муциновой оболочкой)по Романовскому-Гимзе – в бледно-розовый цвет
Слайд 17T. pallidum, вариант pallidum: культивирование
«культуральные трепонемы» - теряют вирулентность и
изменяют другие свойства
среды с почечной или мозговой тканью
строгие анаэробные условия
350
Смедленный рост
«тканевые трепонемы» - сохраняют вирулентность и другие свойства
ткань яичка кролика
Слайд 19T. pallidum, вариант pallidum: антигенная структура
плохо изучена
сложна
известны:
трепонематозный (специфические) термолабильный белковый
липоидный
(неспецифический) – идентичен липоидному экстракту бычьего сердца
N
Слайд 20T. pallidum, вариант pallidum: факторы вирулентности
устойчивость к фагоцитозу
высокая инвазивная активность
эндотоксин
липопротеины
(участвуют в развитии иммунопатологических процессов)
Слайд 22Сифилис: взаимодействие возбудителя с организмом человека
размножение трепонем в месте внедрения
твёрдый
шанкр региональный
лимфоадениткровь сыпь
диссеминация по органам гранулемы
мозг нейросифилис
первичный сифилис
вторичный сифилис
третичный сифилис
Слайд 23Сифилис: общая характеристика заболевания
циклическое
стадии (периоды) не всегда сменяются последовательно
образование L-форм
и цист
Слайд 24Сифилис: периоды
инкубационный
первичный сифилис
вторичный сифилис
третичный сифилис
нейросифилис (четвертичный сифилис)
Слайд 27Сифилис: характеристика первичного периода
в месте внедрения возбудителя – язва (твёрдый
шанкр)
через 7-10 суток – региональный лимфаденит
постепенно твёрдый шанкр рубцуется
Илл.
Слайд 29Сифилис: характеристика вторичного периода
наступает через 6-7 недель после появления твёрдого
шанкра
рецидивирующая сыпь
Илл.
Слайд 32Сифилис: исходы вторичного периода
25 % - выздоровление
25 % - переход
в латентную фазу (длится от 3 до 30 лет)
50 %
- переход в третичный периодИлл.
Слайд 33Сифилис: характеристика третичного периода
наступает обычно через 3-4 года после заражения
гуммы
(гранулёмы)
распад, рубцевание
серьёзные нарушения функции внутренних органов (висцеральный сифилис)
Илл.
Слайд 35Характеристика нейросифилиса
развивается у некоторых больных при неадекватном лечении
наступает в среднем
через 8-15 лет
тяжёлое поражение ЦНС
Илл.
Слайд 37Врождённый сифилис: условия возникновения
инфицирование плода во вторую половину беременности
инфицирование ребёнка
при прохождении через родовые пути больной женщины
Слайд 39Сифилис: особенности иммунитета
восприимчивость человека к сифилису
клеточный ИО
инфекционная аллергия (ГЗТ)
гуморальный ИО
постинфекционный
иммунитет
высока
фиксация (гранулёмы)
не элиминируют
не эффективен
не формируется
Слайд 40Сифилис: механизм формирования рецидивирующей сыпи
высота ИО
образование цист
снижение напряжённости ИО
возврат в
вегетативную форму
стадия ремиссии
рецидив
Слайд 41Сифилис: источник и механизм передачи
источник инфекции – человек (в первичной
и вторичной стадии)
основной механизм передачи – контактный (чаще – половой)
дополнительный
механизм передачи – трансплацентарный (начиная с 5 месяца беременности)Слайд 42Сифилис: устойчивость возбудителя к факторам внешней среды
малоустойчив вне организма человека
чувствителен
к дезинфектантам
долго сохраняется во влажной среде (в матерчатых тканях –
до 50 суток)Слайд 43Сифилис: профилактика
Неспецифическая
постоянный половой партнёр
выявление и лечение больных
обследование
доноров
беременных (лечение в первую
половину беременности)
групп риска (наркоманов, лиц, практикующих промискуитет)
Специфическая
не разработана
Илл.
Слайд 46Микроскопическое выявление
T. pallidum
микроскопия нативного препарта в тёмном поле
длительная окраска
по Романовскому-Гимзе
обработка серебрением (по Морозову)
Слайд 50Оценка микроскопической картины при выявлении
T. pallidum
дифференциация от нитей фибрина
дифференциация
сапрофитических трепонем от T. pallidum
Слайд 51Дифференциация сапрофитических трепонем от
T. pallidum
на наружных половых органах –
T. refringens
выраженная подвижность
отсутствие сгибательных движений
в ротовой полости – T. denticola
короткие
завиткиостроугольная форма завитков
Слайд 52Серологический метод диагностики сифилиса
Неспецифические тесты
(с кардиолипиновым антигеном)
РСК (Вассермана)
РП на
стекле (предварительное обследование)
Специфические тесты
(с трепонематозным антигеном)
РСК (Вассермана)
реакция иммобилизации
РИФ
ИФА
РНГА
N
Слайд 54Бытовые трепонематозы: распространение
фрамбезия – тропические страны
пинта – эндемичные очаги в
прибрежных районах Ц. Америки, Экв. Африки, южной Азии
беджель – эндемичные
очаги в Африке, на Балканах, в Турции, на Аравийском полуострове, в Индии, Пакистане, Австралии и ГаитиИлл.
Слайд 55Бытовые трепонематозы: пути заражения
фрамбезия – контактный (очень редко половой) через
повреждённые кожные покровы, может передаваться мухами
пинта – как при фрамбезии
беджель
– контактный, через повреждённые кожные покровы, наиболее часто болеют дети 2-10 летСлайд 56Бытовые трепонематозы: клинические проявления
фрамбезия – как при сифилисе; прогноз благоприятный,
хотя может затягиваться до 30 лет, развивается стойкий постинфекционный иммунитет
пинта
– появление на коже красных или сине-фиолетовых пятен с последующим формированием на их месте очагов депигментации; может развиваться полиаденит, реже – поражения внутренних органов, нервной системы и костейбеджель – как при вторичном и третичном сифилисе (но поражения внутренних органов не развиваются)
Илл.
Слайд 57Бытовые трепонематозы: диагностика
фрамбезия –
пинта –
беджель –
учитывая клинические и эпидемиологические особенности заболевания
– микроскопия
– обнаружение
антител– РСК
– РИФ
N
Слайд 60Основные группы патогенных для человека боррелий
возбудитель эпидемического возвратного тифа
платяная вошь
возбудители
клещевых спирохетозов (эндемических возвратных тифов)
клещи-орнитодорины
возбудителя болезни Лайма
иксодовые клещи
Слайд 61Свойства боррелий
похожи на червей
строгие анаэробы
среды с животными белками, куриные эмбрионы
Слайд 62Антигенная структура боррелий
сложная
внутригеномная рекомбинация → чрезвычайная вариабельность
Слайд 64Эпидемический возвратный тиф: этиология
Borrelia recurrentis (размножается в гемолимфе платяных вшей)
Слайд 65Эпидемический возвратный тиф: взаимодействие возбудителя с организмом человека
B.recurrentis
клетки лимфомакрофагальной системы
выход
в кровь
лизис Ig-ами
агрегированиес тромбоцитами
освобождение приступ нарушение
от преобладающего лихорадки местного
серовара кровообращения
сохранение других сероваров
5 – 6 приступов
Слайд 67Эпидемический возвратный тиф: микробиологическая диагностика
кровь (приступ)
мазок
предв.
DS
морская свинказдорова больна
эпидемич.в.т. эндемич. в.т.
N
микроскопия крови через 2 – 4 суток
Слайд 71Клещевые спирохетозы: эндемичные очаги
расположены на всех континентах, кроме Австралии
для каждого
природного очага – свой вариант возбудителя
Слайд 72Клещевые спирохетозы: возбудители
B. duttoni
B. uzbekistanica
B. persica
B. caucasica
и др.
друг от друга
отличаются антигенной структурой
Слайд 74Болезнь Лайма: этиология
B. burgdorferi
B. garinii
B. afzelii
друг от друга отличаются антигенной
структурой
Слайд 77Болезнь Лайма
Источники инфекции – мелкие грызуны, олени, лоси
Переносчики – Ixodes
(ареал обитания = район распространения болезни Лайма)
Слайд 79Болезнь Лайма: взаимодействие возбудителя с организмом человека
укус клеща (слюна)
папула
кровь
поражения внутренних
органов
(аутоиммунный компонент)
Слайд 81Болезнь Лайма: общая характеристика болезни
Локальное поражение кожи (кольцевая мигрирующая эритема)
Поражение
(хронический процесс):
суставов
сердечно-сосудистой системы
нервной системы
N
Слайд 83Болезнь Лайма: микробиологическая диагностика
Выделение культуры из ткани эритемы, крови, ликвора
(трудно)
Ag в ткани эритемы (РИФ)
Выявление Ig (иммуноблоттинг)
IgM (на 3-6 неделе
после инфицирования)IgG (через неск. месяцев после инфицирования)
ПЦР
N
Слайд 85Лептоспиры: общая классификация
Leptospira
водные
патогенные
(сапрофитические)
(L.interrogans)лептоспироз
N
(L.biflexa)
Слайд 86Лептоспиры: морфологические свойства
толщина 0,1 мкм
завитки первого порядка («верёвка»)
завитки второго порядка
(S или С)
на концах – по одному периплазматическому жгутику
Слайд 88Лептоспиры: основной способ микроскопического выявления
Тёмно-польная микроскопия «раздавленной капли»
Слайд 91Лептоспиры: культуральные свойства
микроаэрофилы
30о С
жидкие и полужидкие среды с сывороткой кролика
(напр., Уленгута)
~ неделя
не мутят (микроскопия)
Слайд 92Серогруппы и серовары патогенных лептоспир
более 200 сероваров
в СНГ – 27
объединены
в 38 серогрупп
в СНГ - 13
Слайд 93Чувствительность лептоспир к факторам внешней среды
солнечный свет
высокая температура
высушивание
дезинфектанты
Долго сохраняются в
заболоченной почве (до 200 суток)
Слайд 94Факторы патогенности лептоспир
эндотоксин
общая интоксикация
геморрагии
высокая подвижность
инвазивность
устойчивость к фагоцитозу
ферменты вирулентности
фибринолизин
плазмокоагулаза
липаза
цитотоксины и гемолизин
N
Слайд 97Лептоспироз: особенности инфицирования человека
животные
с мочой
инфицирование объектов внешней среды
воды (чаще)
почвы
пищевых продуктов
контакт
человека
слизистые
повреждённая кожа
Слайд 98Взаимодействия лептоспир с организмом человека
покровы
лимфа
nodulus
кровь
сосуды
печень
почки
ЦНС
геморрагии
желтуха
в моче
менингизм
Слайд 100Патогенез поражения при лептоспирозе сосудов
механическое воздействие на эндотелий
нарушение проницаемости стенки
множественные
геморрагии
Илл.
Слайд 101Патогенез поражения при лептоспирозе печени
механическое повреждение гепатоцитов активно подвижными лептоспирами
токсическое
действие метаболитов и продуктов распада лептоспир
Илл.
Слайд 102Патогенез поражения при лептоспирозе почек
избирательное депонирование лептоспир
на поверхности эпителиальных клеток
в
межклеточном пространстве
тяжёлое повреждение почечных канальцев
нарушение мочеобразования
Илл.
Слайд 103Патогенез поражения при лептоспирозе ЦНС
непосредственное действие самих бактерий
действие их токсинов
действие
продуктов распада бактериальных клеток
менингиальные явления
Илл.
Слайд 105Лабораторная диагностика лептоспироза: общая схема
патологический материал
serum
микроскопия выделение биопроба Ig
культурыокончательный диагноз
N
ПЦР
Слайд 106Лабораторная диагностика лептоспироза: патологический материал
кровь – 1 неделя
моча – со
2 недели
liquor – при менингиальных симптомах
Слайд 107Лабораторная диагностика лептоспироза: микроскопический метод
«раздавленная капля»
микроскопия в тёмном поле
– малочувствителен
–
недостаточно специфичен
N
Слайд 108Лабораторная диагностика лептоспироза: культуральный метод
среда Уленгута
микроскопия каждые 2 дня
реакция микроагглютинации
и лизиса
Слайд 110Лабораторная диагностика лептоспироза: биологический метод
внутрибрюшинно
морская свинка
потеря веса
желтуха
экссудат из брюшной полости
РМАиЛ
культура
Слайд 111Лабораторная диагностика лептоспироза: серологический метод
со второй недели заболевания
реакция микроагглютинации и
лизиса, РСК
с поливалентным диагностикумом (т.к. нет перекрёстного иммунитета)
до очень высоких
титровдолго сохраняется
N